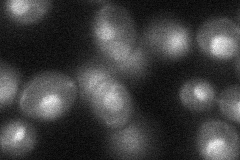
YLR336C
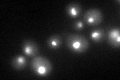
YLR336C

View description
Essential nuclear protein with a possible role in the osmoregulatory glycerol response; interacts with phospholipase C (Plc1p); putative homolog of human NOM1 which is implicated in acute myeloid leukemia
Localization:
Intensity:
Fold change:
Significance:
-
C’ GFP library in SD

nucleolus44.98 -
N' NOP1pr-GFP in SD

nucleus73.7349 -
N' TEF2pr-mCherry in SD

nucleusN/A -
N' NATIVEpr-GFP in SD

below threshold19.9597 -
N' TEF2pr-VC and Cyto-VN in SD
nucleus,nucleolus38.9806 -
C’ GFP library in SD+DTT
nucleolus34.520.76No -
C’ GFP library in SD+H2O2

nucleolus39.040.86No -
C’ GFP library in Starvation Media

nucleolus25.960.57Yes -
C’ GFP library on the background of Pup2-DaMP

nucleolus -
C’ GFP library on the background of CCT mutant

nucleolus47.16461.04826No
